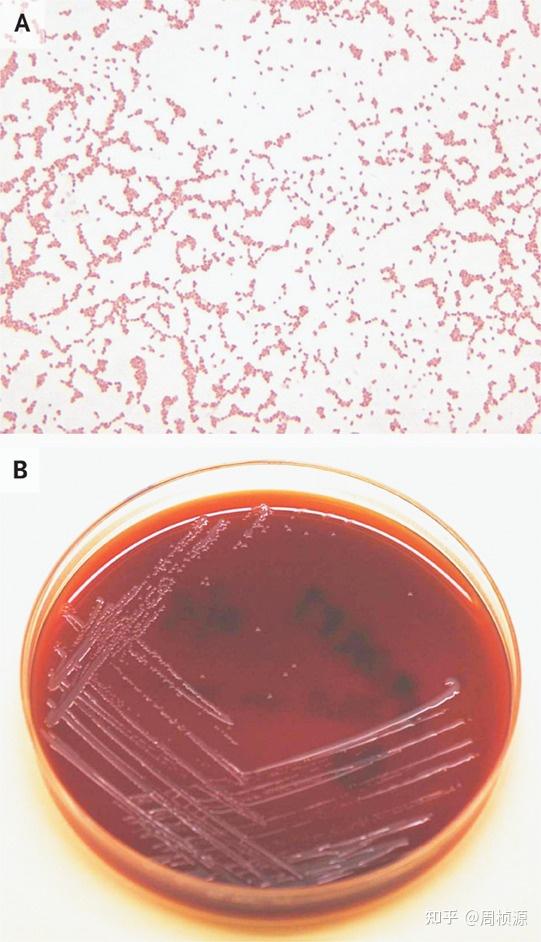
诊断结果来自于3套有氧和厌氧菌血养瓶.住院第1天在急诊采血.

布鲁菌革兰染色

布鲁氏菌革兰氏染色图
图片尺寸640x510
组织病理学, 豚鼠, 脾脏, 实验, 猪布鲁氏杆菌, 感染
图片尺寸550x438
布鲁氏菌为小球杆状菌,革兰氏染
图片尺寸175x176
一例儿童马耳他布鲁氏菌血流感染病例分享
图片尺寸623x956
布鲁菌菌落形态(血平板72h)布鲁菌在镜下为革兰染色阴性球杆状细菌,其
图片尺寸552x412
一例儿童马耳他布鲁氏菌血流感染病例分享
图片尺寸641x1031
长沙市中医医院收治首例布鲁氏菌病他们是如何发现的
图片尺寸1000x391
病例布鲁菌引起儿童血流感染
图片尺寸780x768
图2 布鲁菌革兰氏染色形态然后上梅里埃vitek2compact微生物鉴定仪
图片尺寸660x582
图6 大肠埃希菌和布鲁菌混合涂片,柯兹洛夫斯基染色镜下形成红色细沙
图片尺寸660x858
假报阳布鲁氏菌在伪装
图片尺寸332x331
涂片革兰染色,见革兰阴性小杆菌,报告临床医生,并转种于平板培养,24
图片尺寸259x345
染色经飞行时间质谱(maldi-tof)鉴定为少见的盖尔森基兴诺卡菌(图8)
图片尺寸535x533
大家给看一下这个痰标本革兰氏染色 2015-12-18 11:12 关注
图片尺寸576x1024
图6 革兰染色镜下形态(1000倍)图7 布鲁菌抗体三项案例分析人类对布鲁
图片尺寸660x677
羊布鲁氏菌革兰氏染色.
图片尺寸1200x834
图一是尿液标本离心后取沉淀,革兰染色后油镜,可以看到少量的阴性杆菌
图片尺寸1080x1440
爱冒险夏日计划 金葡菌的革兰染色:g
图片尺寸1080x1439
找病原 湿片法 阳性率 ns 30-50% 10%koh 70-80% 染色法 革兰
图片尺寸960x720
诊断结果来自于3套有氧和厌氧菌血养瓶.住院第1天在急诊采血.
图片尺寸541x942